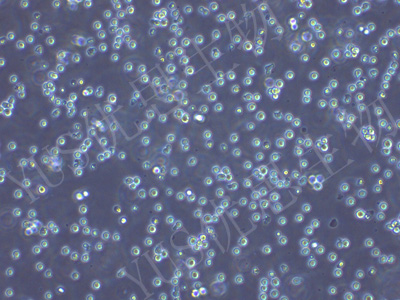
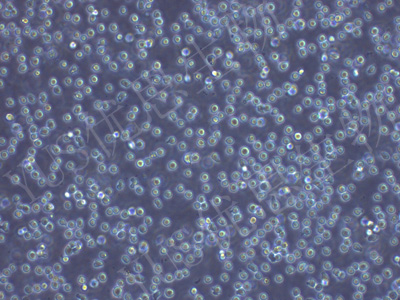

产品中心
产品中心
-

HBL-100 人整合SV40基因的乳腺上皮细胞(STR鉴定)
货号:YLH410规格: 1*10^6 -

DMS114 人小细胞肺癌细胞(STR鉴定)
货号:YLH411规格: 1*10^6 -

Caki-2 人乳头状肾细胞癌细胞(STR鉴定)
货号:YLH412规格: 1*10^6 -
H9 人T淋巴瘤细胞系(STR鉴定)
货号:YLH413规格: 1*10^6 -

U251MG 人类星型胶质细胞瘤(STR鉴定)
货号:YLH414规格: 1*10^6 -

D283Med 人脑髓母细胞瘤细胞(STR鉴定)
货号:YLH415规格: 1*10^6 -
HMy2.CIR 人B淋巴母细胞(STR鉴定)
货号:YLH416规格: 1*10^6 -

BT-549 人乳腺管癌细胞(STR鉴定)
货号:YLH417规格: 1*10^6 -

CCRF-CEM 人急性淋巴细胞白血病T淋巴细胞(STR鉴定)
货号:YLH418规格: 1*10^6 -

KYSE-150 人食管癌细胞(STR鉴定)
货号:YLH419规格: 1*10^6 -

Nthy-ori 3-1 人甲状腺正常细胞(STR鉴定)
货号:YLH420规格: 1*10^6 -

SNU-16 人胃癌细胞(STR鉴定)
货号:YLH421规格: 1*10^6
在线咨询
Online consultation

关注微信公众号


